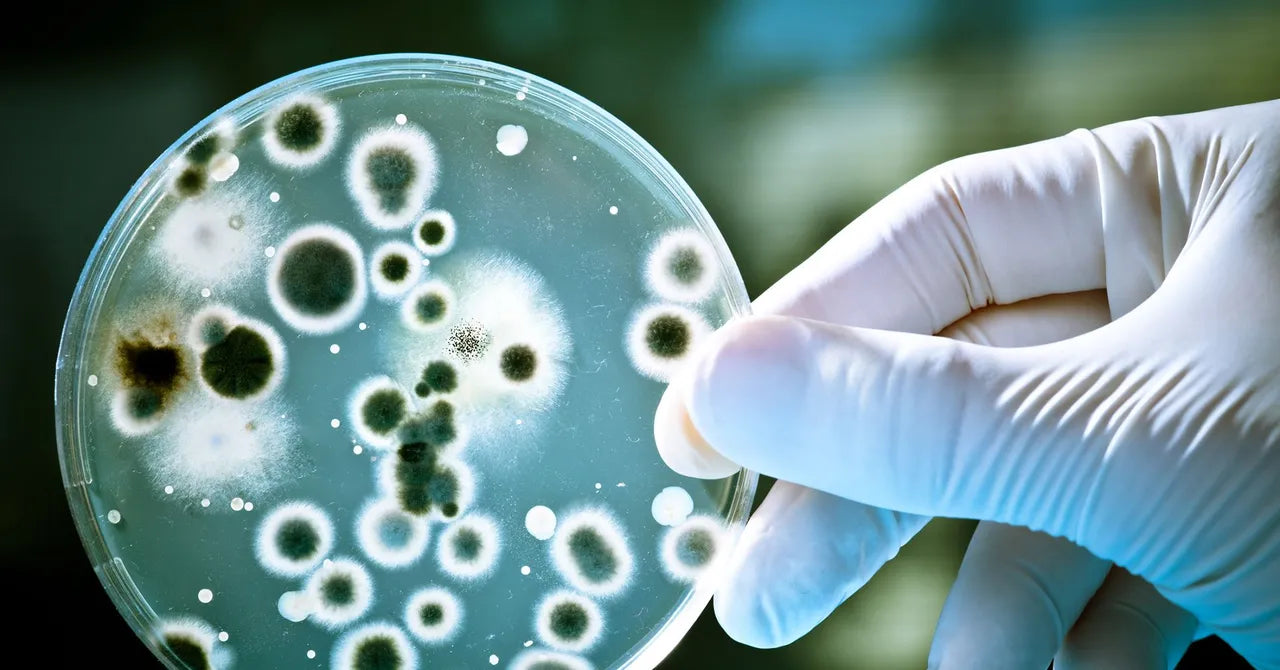
Housse de Siège Protectrice – Voyage Train, Avion & Transport Public (Lot de 4 et 6)

1
/
de
14
ysofresh
Housse de Siège Protectrice – Voyage Train, Avion & Transport Public (Lot de 4 et 6)
Housse de Siège Protectrice – Voyage Train, Avion & Transport Public (Lot de 4 et 6)
Prix habituel
€34,90 EUR
Prix habituel
€34,90 EUR
Prix promotionnel
€34,90 EUR
Frais d'expédition calculés à l'étape de paiement.
Quantité
Impossible de charger la disponibilité du service de retrait
Description
Taille: 150*60cm
Coleur: Blanc
Features: light and breathable
Pour deplacement en train, avion, cinema
Pack inclus: /4/6

100 % confort :
-
Matière douce et respirante
-
Agréable au contact de la peau
-
Ne colle pas, ne gratte pas, ne glisse pas
🧼 Protection hygiénique optimale :
-
Limite le contact avec les surfaces publiques
-
Idéal pour les longs trajets
-
Parfait pour les voyageurs fréquents, familles et professionnels
🎒 Pratique & léger :
-
Facile à transporter
-
Installation rapide sur la majorité des sièges
-
S’adapte aux sièges de train, avion et transports collectifs
🌍 Indispensable pour vos déplacements :










Share